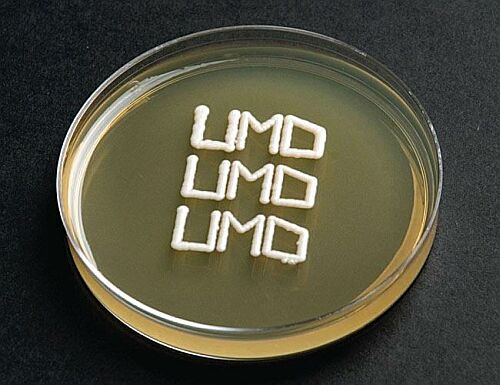

Notice: Undefined offset: 6 in /var/www/www-root/data/www/374.ru/tpl_text/text_picture.php on line 73
![]() |
В самом последнем исследовании австралийский исследователь попросил, чтобы 23 испытуемых произносили речь после использования маленьких доз DCS и прохождения терапии подвергания. Затем он сравнил результаты с пациентами, которые также произносили речь, но никаким способом не лечили свои фобии.
Доктор Адам Гуастелла из университета Нового Южного Уэльса, сказал, что различие между этими двумя группами было удивительным. “Эти люди были настолько застенчивы, что не могли входить в переполненную комнату или говорить публично”.
Однако те, кто получил DCS, показали большое сокращение опасений и сообщили о длительном усовершенствовании навыков построения социальных отношений”.
Исследование в Америке показало, что 13 из 100 человек страдают от социальных фобий. Волнуются, когда за ними наблюдают, оценивают или критикуют публично. Люди обычно показывают первые признаки социальных страхов в возрасте 15 лет, но они могут продолжать существовать у человека в течение долгого времени, если их не лечить.
Ученые говорят, что DCS сам по себе не имеет никакого лечебного эффекта, но увеличивает действие терапии через изменение нейротрансмиттеров в мозгу, связанных с обучением преодоления фобий.
Хотите прокомментировать?
Кроме того...
Прокат-автомат выдаёт и глотает велосипеды
Удобство любой системы...
LBook eReader - устройство для чтения электронных книг
Появилось электронное...
G
...